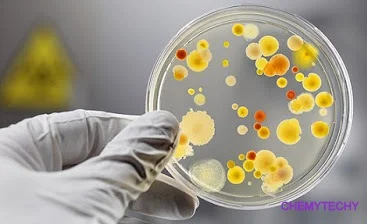
¿Por qué es importante conocer la historia de la microbiología para su disciplina como enfermero?

-
-
BRAYAN BOHORQUEZ
JOHAN BARRERA
DIANA CASTRO
NATALIA PLAZAS -
 Fue el primero en refutar la teoría de la generación espontánea en gusanos.
Fue el primero en refutar la teoría de la generación espontánea en gusanos. -
 Es el primero en observar bacterias o "animálculos"
Es el primero en observar bacterias o "animálculos" -
 Desarrolla la primera vacuna contra la viruela humana.
Desarrolla la primera vacuna contra la viruela humana. -
 muestra que la enfermedad que afectaba al gusano de seda (Muscardine disease) era causada por un hongo (botrytis bassiana) y se reconoce que es el primer agente infeccioso que afecta a un animal.
muestra que la enfermedad que afectaba al gusano de seda (Muscardine disease) era causada por un hongo (botrytis bassiana) y se reconoce que es el primer agente infeccioso que afecta a un animal. -
 Descubre un hongo (Phyto phthora infestans) que produce la podredumbre de la patata.
Descubre un hongo (Phyto phthora infestans) que produce la podredumbre de la patata. -
 El contagio de la fiebre puerperal. (Lo importante de lavarse las manos).
El contagio de la fiebre puerperal. (Lo importante de lavarse las manos). -
 Realiza el primer estudio epidemiológico del cólera en
Realiza el primer estudio epidemiológico del cólera en
Londres. -
 Refuta de manera convincente la teoría de la generación
Refuta de manera convincente la teoría de la generación
espontánea. -
 Desarrollo mediante la practica quirúrgica de la asepsia y la antisepsia
Desarrollo mediante la practica quirúrgica de la asepsia y la antisepsia -
 Aisló varias moléculas ricas en fosfatos, a las cuales llamó nucleínas, a partir del núcleo de los glóbulos blancos en 1869, y así preparó el camino para su identificación como los portadores de la información hereditaria, el ADN.
Aisló varias moléculas ricas en fosfatos, a las cuales llamó nucleínas, a partir del núcleo de los glóbulos blancos en 1869, y así preparó el camino para su identificación como los portadores de la información hereditaria, el ADN. -
 Construye a la fundamentación de la bacteriología. Realiza una temprana clasificación de las bacterias usando el termino Bacillos por primera vez.
Construye a la fundamentación de la bacteriología. Realiza una temprana clasificación de las bacterias usando el termino Bacillos por primera vez. -
 Demuestra que el carbunco o ántrax (Cutáneo, Heridas) es causado por Bacilo
Demuestra que el carbunco o ántrax (Cutáneo, Heridas) es causado por Bacilo
antracis. -
 Lister, contribuyó a reducir en gran medida el número de muertes por infecciones contraídas en el quirófano.
Lister, contribuyó a reducir en gran medida el número de muertes por infecciones contraídas en el quirófano. -
 Observa que la fiebre amarilla es transmitida por mosquitos.
Observa que la fiebre amarilla es transmitida por mosquitos. -
 descubre el Mycobacterium tuberculosis.
descubre el Mycobacterium tuberculosis. -
 Demostró que los microorganismos no se formaban espontáneamente, refutando así la teoría de la generación espontánea y demostrando que todo ser vivo procede de otro ser vivo anterior.
Demostró que los microorganismos no se formaban espontáneamente, refutando así la teoría de la generación espontánea y demostrando que todo ser vivo procede de otro ser vivo anterior. -
 Descubre Escherichia coli. Produciendo toxinas al intestino delgado
Descubre Escherichia coli. Produciendo toxinas al intestino delgado -
 Introduce el uso de las placas Petri en Microbiología
Introduce el uso de las placas Petri en Microbiología -
 Aísla bacterias fijadoras de nitrógeno de los nódulos presentes en las raíces de leguminosas.
Aísla bacterias fijadoras de nitrógeno de los nódulos presentes en las raíces de leguminosas. -
 Estudia las bacterias del azufre y las bacterias nitrificantes
Estudia las bacterias del azufre y las bacterias nitrificantes
. -
 Demuestra que el mosaico del tabaco es producido por un virus
Demuestra que el mosaico del tabaco es producido por un virus -
 Confirma que la fiebre amarilla es transmitida por mosquitos, hecho previamente observado por Carlos Finlay en 1881.
Confirma que la fiebre amarilla es transmitida por mosquitos, hecho previamente observado por Carlos Finlay en 1881. -
 Descubre el salvarsán (balas mágicas), primer agente quimioterapé utico contra la sífilis
Descubre el salvarsán (balas mágicas), primer agente quimioterapé utico contra la sífilis -
 Descubre el virus (retrovirus) que produce tumores (sarcomas) en pollos.
Descubre el virus (retrovirus) que produce tumores (sarcomas) en pollos. -
 Descubre los virus que infectan bacterias (bacteriófagos).
Descubre los virus que infectan bacterias (bacteriófagos). -
 Descubre más virus bacteriófagos.
Descubre más virus bacteriófagos. -
 LLeva a cabo el descubrimiento de la transformación
LLeva a cabo el descubrimiento de la transformación
bacteriana. -
 Aísla la penicilina de un cultivo de Penicillium notatum
Aísla la penicilina de un cultivo de Penicillium notatum
. -
 Desarrolla el microscopio de contraste de fases que permite ver microorganismos vivos
Desarrolla el microscopio de contraste de fases que permite ver microorganismos vivos
. -
 Descubre los priones, agentes causantes de la encefalopatía espongiforme bovina y de la enfermedad de
Descubre los priones, agentes causantes de la encefalopatía espongiforme bovina y de la enfermedad de
Creutzfeldt -Jakob. -
 Utilizó la Taq polimerasa para llevar a cabo la PCR (reacción en cadena de la polimerasa).
Utilizó la Taq polimerasa para llevar a cabo la PCR (reacción en cadena de la polimerasa). -
 Descubren que Vibrio cholerae tiene dos cromosomas circulares
Descubren que Vibrio cholerae tiene dos cromosomas circulares -
 Realizaron la secuenciación del genoma de Streptomyces
Realizaron la secuenciación del genoma de Streptomyces
coelicolor. -
Conocer la historia de la microbiología es fundamental para los enfermeros, ya que les proporciona una base sólida de conocimientos sobre los microorganismos, las medidas de control de infecciones y el uso de antimicrobianos. Esto les permite brindar una atención de calidad, prevenir la propagación de enfermedades y educar a los pacientes sobre la importancia de mantener una buena salud.
Conocer la historia de la microbiología es fundamental para los enfermeros, ya que les proporciona una base sólida de conocimientos sobre los microorganismos, las medidas de control de infecciones y el uso de antimicrobianos. Esto les permite brindar una atención de calidad, prevenir la propagación de enfermedades y educar a los pacientes sobre la importancia de mantener una buena salud. -
 Louis Pasteur y Robert Koch son considerados los padres de la microbiología moderna debido a sus trascendentales contribuciones a esta disciplina científica. Ambos científicos realizaron descubrimientos fundamentales que sentaron las bases de la microbiología y revolucionaron nuestra comprensión de los microorganismos y su relación con la salud y las enfermedades.
Louis Pasteur y Robert Koch son considerados los padres de la microbiología moderna debido a sus trascendentales contribuciones a esta disciplina científica. Ambos científicos realizaron descubrimientos fundamentales que sentaron las bases de la microbiología y revolucionaron nuestra comprensión de los microorganismos y su relación con la salud y las enfermedades. -
 Es conocido por sus avances en microbiología, que incluyen la refutación de la teoría de la generación espontánea y el desarrollo de la técnica de pasteurización. Pasteur demostró que las enfermedades estaban relacionadas con microorganismos y que estos podían ser cultivados y estudiados. Sus investigaciones sentaron las bases de la microbiología médica y condujeron al desarrollo de vacunas contra enfermedades como el carbunco, el cólera aviar y la rabia.
Es conocido por sus avances en microbiología, que incluyen la refutación de la teoría de la generación espontánea y el desarrollo de la técnica de pasteurización. Pasteur demostró que las enfermedades estaban relacionadas con microorganismos y que estos podían ser cultivados y estudiados. Sus investigaciones sentaron las bases de la microbiología médica y condujeron al desarrollo de vacunas contra enfermedades como el carbunco, el cólera aviar y la rabia. -
 Contribuyó de manera decisiva al estudio de las enfermedades infecciosas. Utilizando los llamados postulados de Koch, demostró que enfermedades específicas estaban causadas por microorganismos patógenos específicos. Koch fue uno de los primeros científicos en obtener cultivos puros de bacterias, que le permitió aislar y describir varias especies bacterianas. Sus descubrimientos sentaron las bases de la bacteriología médica y establecieron la relación directa microorganismos y las enfermedades.
Contribuyó de manera decisiva al estudio de las enfermedades infecciosas. Utilizando los llamados postulados de Koch, demostró que enfermedades específicas estaban causadas por microorganismos patógenos específicos. Koch fue uno de los primeros científicos en obtener cultivos puros de bacterias, que le permitió aislar y describir varias especies bacterianas. Sus descubrimientos sentaron las bases de la bacteriología médica y establecieron la relación directa microorganismos y las enfermedades. -
(N.d.-a). Retrieved February 14, 2024, from http://file:///C:/Users/eduar/Downloads/Personajes-hist%C3%B3ricos.pdf (N.d.-b). Retrieved February 14, 2024, from http://file:///C:/Users/eduar/Downloads/Historia_de_la_microbiologia_y_la_microb.pdf (N.d.-c). Retrieved February 14, 2024, from http://file:///C:/Users/eduar/Downloads/Li%CC%81nea%20del%20tiempo%20de%20la%20microbiologi%CC%81a%20(1).pdf